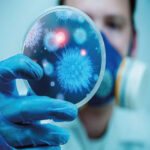

Şalgam Suyunun Faydaları Neledir? Şalgam suyu, şalgam kökü veya suyunun fermente edilerek elde edildiği bir içecektir. Bu içeceğin tüketilmesi, birçok sağlık yararı sağlar. Şalgam suyu, şalgam kökünün su veya tuz içerisinde fermente edilmesi ile elde edilen bir içecektir. Türk mutfağında özellikle kış aylarında tüketilen şalgam suyu, sağlık açısından birçok potansiyel fayda sağlar.

C Vitamini ve Antioksidan İçeriği:
Şalgam Suyunun Faydaları Neledir?
- Şalgam suyu, C vitamini ve diğer antioksidanları içerir. Bu, vücuttaki serbest radikallerle savaşarak hücre hasarını önler ve bağışıklık sistemini destekler.
Mineral ve Vitamin Deposu:
- Potasyum, demir, kalsiyum ve B vitaminleri gibi bir dizi mineral veya vitamin içerir. Bu, kemik sağlığını, enerji üretimini veya sinir fonksiyonlarını destekler.
Lif İçeriği ve Sindirim Sağlığı:
- Lif açısından zengin olan şalgam suyu, sindirim sistemi sağlığını destekler. Lif, bağırsak hareketliliğini artırarak kabızlığı önler ve sindirim sürecini düzenlenir.
Anti-inflamatuar Özellikler:
- Anti-inflamatuar özelliklere sahip bileşenler içerir. Bu, vücutta inflamasyonu azaltır veya iltihaplı durumları hafifletir.
Kolesterol Seviyelerini Düşürme:
- Bazı araştırmalar, şalgam suyunun düzenli tüketiminin kan lipid profillerini iyileştirebileceğini veya kolesterol seviyelerini düşürebileceğini göstermektedir.
Karaciğer Sağlığını Destekleme:
- Karaciğerin detoksifikasyon süreçlerini destekler. Karaciğer sağlığına katkıda bulunarak vücudu toksinlerden arındırır.
Kan Basıncını Düşürme:
- İçeriğindeki potasyum, kan basıncını düşürmeye yardımcı olur. Potasyum, sodyumun olumsuz etkilerini dengeleyerek kan damarlarının genişlemesine yardımcı olur.
Anti-Kanser Potansiyeli:
- Bazı araştırmalar, şalgam suyu içinde bulunan glukosinolat adlı bileşiğin, kanser hücrelerine karşı koruyucu olabileceğini göstermektedir. Ancak bu konuda daha fazla araştırma gerekmektedir.
Enerji ve Performansı Artırma:
- İçeriğindeki doğal şekerler veya mineraller, enerji seviyelerini artırabilir ve spor performansını destekler.
Elektrolit Dengesi:
- Potasyum içeriği sayesinde, elektrolit dengesini destekleyebilir. Bu, vücuttaki su dengesini sağlamak için önemlidir.
İdrar Yolu Sağlığı:
- İdrar söktürücü özelliklere sahiptir. Bu, idrar yolu sağlığını destekleyebilir veya böbrek sağlığını olumlu yönde etkileyebilir.
Ancak, bireylerin özel sağlık durumlarına ve ihtiyaçlarına göre farklılık gösterebileceğinden, herhangi bir diyet değişikliği veya takviye kullanımı konusunda bir sağlık uzmanına danışmak önemlidir. Ayrıca, şalgam suyunun tüketilmeden önce doğal fermente edildiğinden emin olunmalı ve herhangi bir katkı maddesi içerip içermediği kontrol edilmeli.
Daha Fazla Bilgi İçin Tıklayınız!!